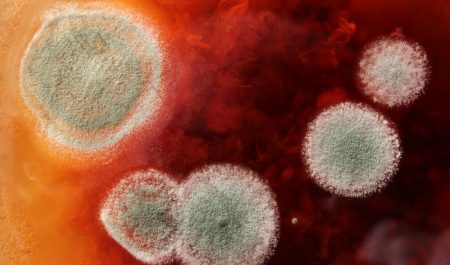

Многие знают, что стеклопакет изготавливают из двух или более стекол, путем герметичного скрепления их в единую конструкцию.
Гораздо меньше людей имеет представление о том, зачем в пространство между образующимися слоями закачивают инертный газ или сухой воздух. В действительности все просто – оба компонента являются отличными тепло и звуко- изоляторами, которые делают окна более теплыми и «тихими».
Воздух и инертный газ проводят тепло почти в 25 раз хуже, чем стеклянные поверхности – то есть большая часть тепла уходит из помещения из-за соприкосновения с холодным стеклом. Чем больше прослоек воздуха будет в стеклопакете, тем лучше он будет сохранять микроклимат в помещении.
На текущий момент имеется три технологии скрепления стекол в стеклопакет: склеивание, спайка и заплавление. Клеить стекла удобнее и быстрее, чем паять или плавить, поэтому с середины XX века при изготовлении пластиковых стеклопакетов применяют только метод склейки.
Оглавление:
Элементы стеклопакета окна
Каждый стеклопакет состоит из совокупности деталей, в число которых обязательно входят стекла, дистанционные рамки, герметические составы, осушители, а также воздух или смесь инертных газов. Перечислим главные элементы.
Стекла
В стеклопакеты окна устанавливают почти все виды стекол, причем в одной конструкции они могут быть как одинаковыми, так и различаться. В зависимости от того, какие дополнительные свойства хотят получить клиенты, стекла в изделии располагают по-разному.
Состав стеклопакета:
Стекла с селективным покрытием устанавливают с внутренней стороны конструкции, а снаружи размещают обычные стекла или изделия с солнцезащитными свойствами. Декоративные, матовые, тонированные или греющие стекла также могут располагаться внутри или снаружи стеклопакета, выполняя полезные функции или просто радуя глаз.
Если стеклопакет планируется использовать с дополнительной нагрузкой (термической, механической, температурной или другой), стоит оценить необходимость упрочнения стекол путем их закалки. При выборе стеклопакета с отражающей защитой от солнца важно не переборщить с его толщиной – чем толще конструкция, тем хуже её эстетичность.
Дистанционные рамки

Для защиты внутреннего пространства стеклопакета от появления конденсата при большой разнице температур, по периметру конструкции между стеклами прокладываются специальные дистанционные рамки. Они изготавливаются из металла или пластика полыми внутри и имеют сквозную перфорацию. Полость рамок заполняется осушителем, который впитывает влагу, в случае её появления внутри стеклопакета. Отверстий на рамках достаточно много, однако они имеют микроскопические размеры, а поэтому не портят внешний вид оконной конструкции.
В современных стеклопакетах чаще всего применяются рамки из алюминия или оцинкованной стали – они эстетичны, прочны и выступают дополнительным каркасом для стеклопакетов. Однако металл хорошо проводит тепло, а поэтому такие изделия становятся «проводниками» холода от внешнего слоя стеклопакета к внутреннему и являются причиной снижения температуры в помещении. Избежать подобного эффекта позволят стеклопакеты с пластиковыми дистанционными рамками, набирающими все большую популярность у покупателей.
Активно развивается производство рамок из современных полимеров, сочетающих в себе свойства рамки, осушителя и герметика. Пластичные рамочные ленты закладываются внутрь стеклопакета или наносятся через экструдер на стеклянную поверхность в зависимости от их состава и консистенции.
Герметизирующие составы

Герметизация стеклопакетов имеет два уровня – внутренний и наружный. Внутренним герметиком, как правило, выступает паста или тонкая лента на основе бутила, идеально защищающая внутреннее пространство от проникновения влаги и водяных испарений.
Процесс герметизации происходит следующим образом: мастику или ленту разогревают до температуры более 100 градусов и накладывают на дистанционную рамку с двух сторон. К рамке с герметиком с усилием прижимаются стекла, вследствие чего образуется тонкий водонепроницаемый шов, практически незаметный для невооруженного глаза. Газо- и водонепроницаемость стеклопакета обеспечивается минимальными размерами шва и высокой диффузионной плотностью бутила.
Как правильно выбирать качественные стеклопакеты?
Пластиковые окна с жалюзи внутри стеклопакета — компактная защита от солнца!
Осушители

Основной задачей осушителей является поглощение влаги, образующейся внутри стеклопакета и предотвращение выступания на поверхности стекла конденсата. Идеальными осушителями для пластиковых окон считаются пористые сорбенты, способные впитывать большое количество влаги. Химический состав осушающего наполнителя может быть однородным или представлять собой комбинацию нескольких веществ. Смешивание материалов производится для того, чтобы максимально снизить точку образования росы – в современных стеклопакетах её значение приближается к – 60 градусам Цельсия.
В зависимости от вида дистанционной рамки, осушитель засыпается в её полость или располагается на поверхности (у современных рамок из полимеров). Его наличие гарантирует сухость внутри конструкции даже при небольшом нарушении герметичности и попадании влаги в стеклопакет. Несмотря на то что осушители максимально снижают температуру, при которой на стеклах образуется конденсат, основной их задачей все же является впитывание влаги, попадающей внутрь при производстве или ремонте, поскольку подобные ситуации встречаются гораздо чаще.
Инертные газы

Пространство между стеклами в стеклопакете наполняется разреженным воздухом или смесью инертных газов. Чаще применяется газовое наполнение, так как оно обеспечивает лучшую теплоизоляцию и защиту помещения от шума. Инертные газы плотнее, чем воздух, а поэтому теплопотери при заполнении ими межстекольного пространства заметно меньше.
Кроме плотности на проводимость тепла влияют и такие характеристики вещества, как теплоемкость, вязкость и т.д. По своим характеристикам лучшими наполнителями для стеклопакетов считаются криптон и аргон, которые выделяют из обычного воздуха после его сжижения. Криптон достаточно дорог, а поэтому в стандартных конструкциях применяется не часто, однако им предпочитают наполнять эксклюзивные стеклопакеты VIP-класса, так как показатели теплоизоляции у него выше.
Толщина стеклопакета

Стеклопакеты для бытовых помещений выпускают толщиной от 16 до 46 мм. Значение параметра зависит от количества камер, толщины и типа стекол. Чем толще стеклопакет, тем он лучше сохраняет тепло, однако увеличение теплоизолирующих свойств не пропорционально значению толщины. После определенного размера, с каждым миллиметром увеличения толщины прирост тепло и звукоизоляции уменьшается, поэтому делать стеклопакеты слишком толстыми не имеет особого смысла.
https://azaoknom.ru "А за Окном"